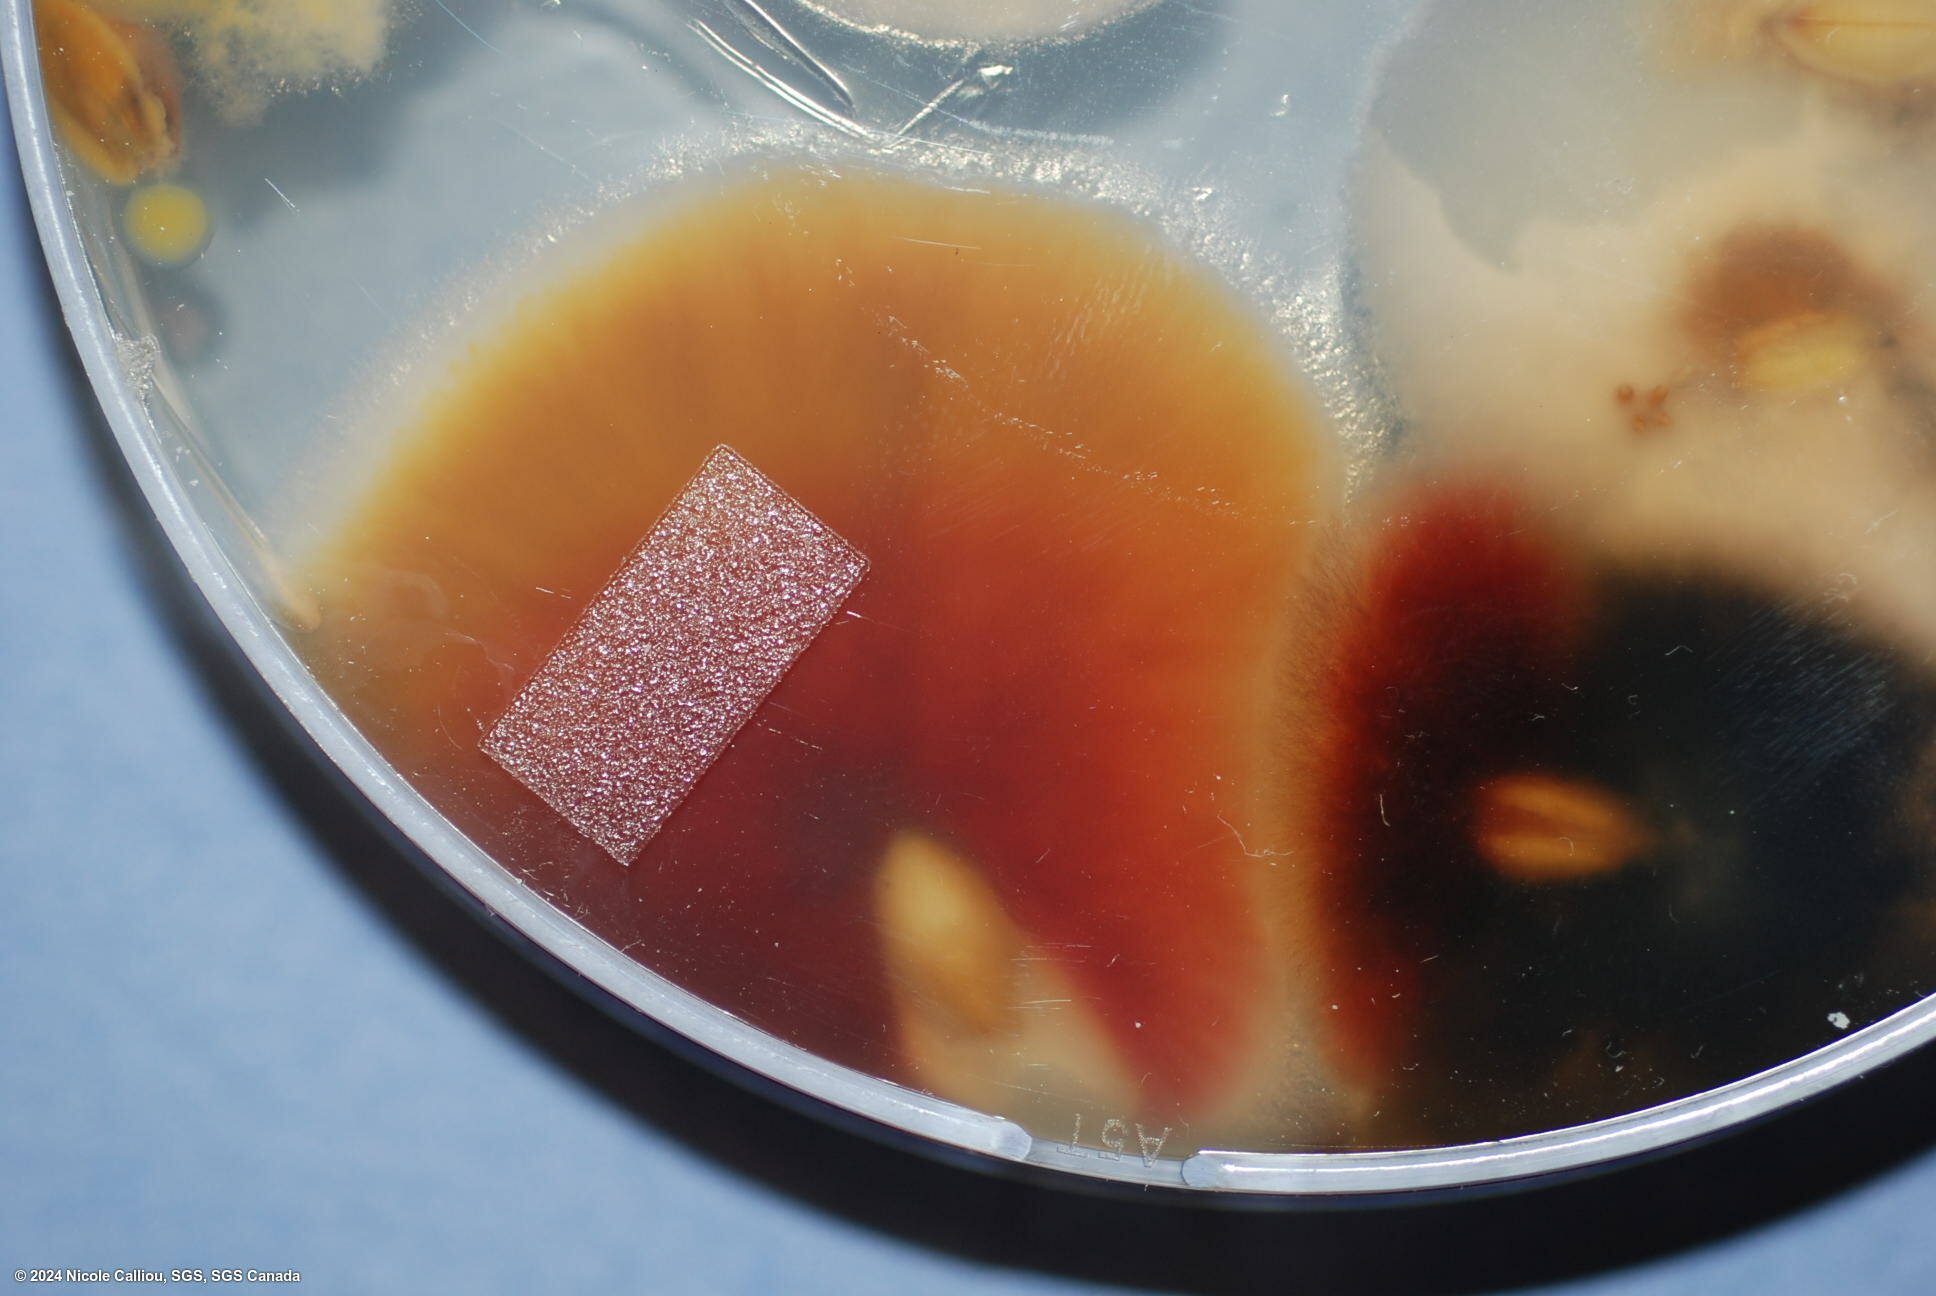
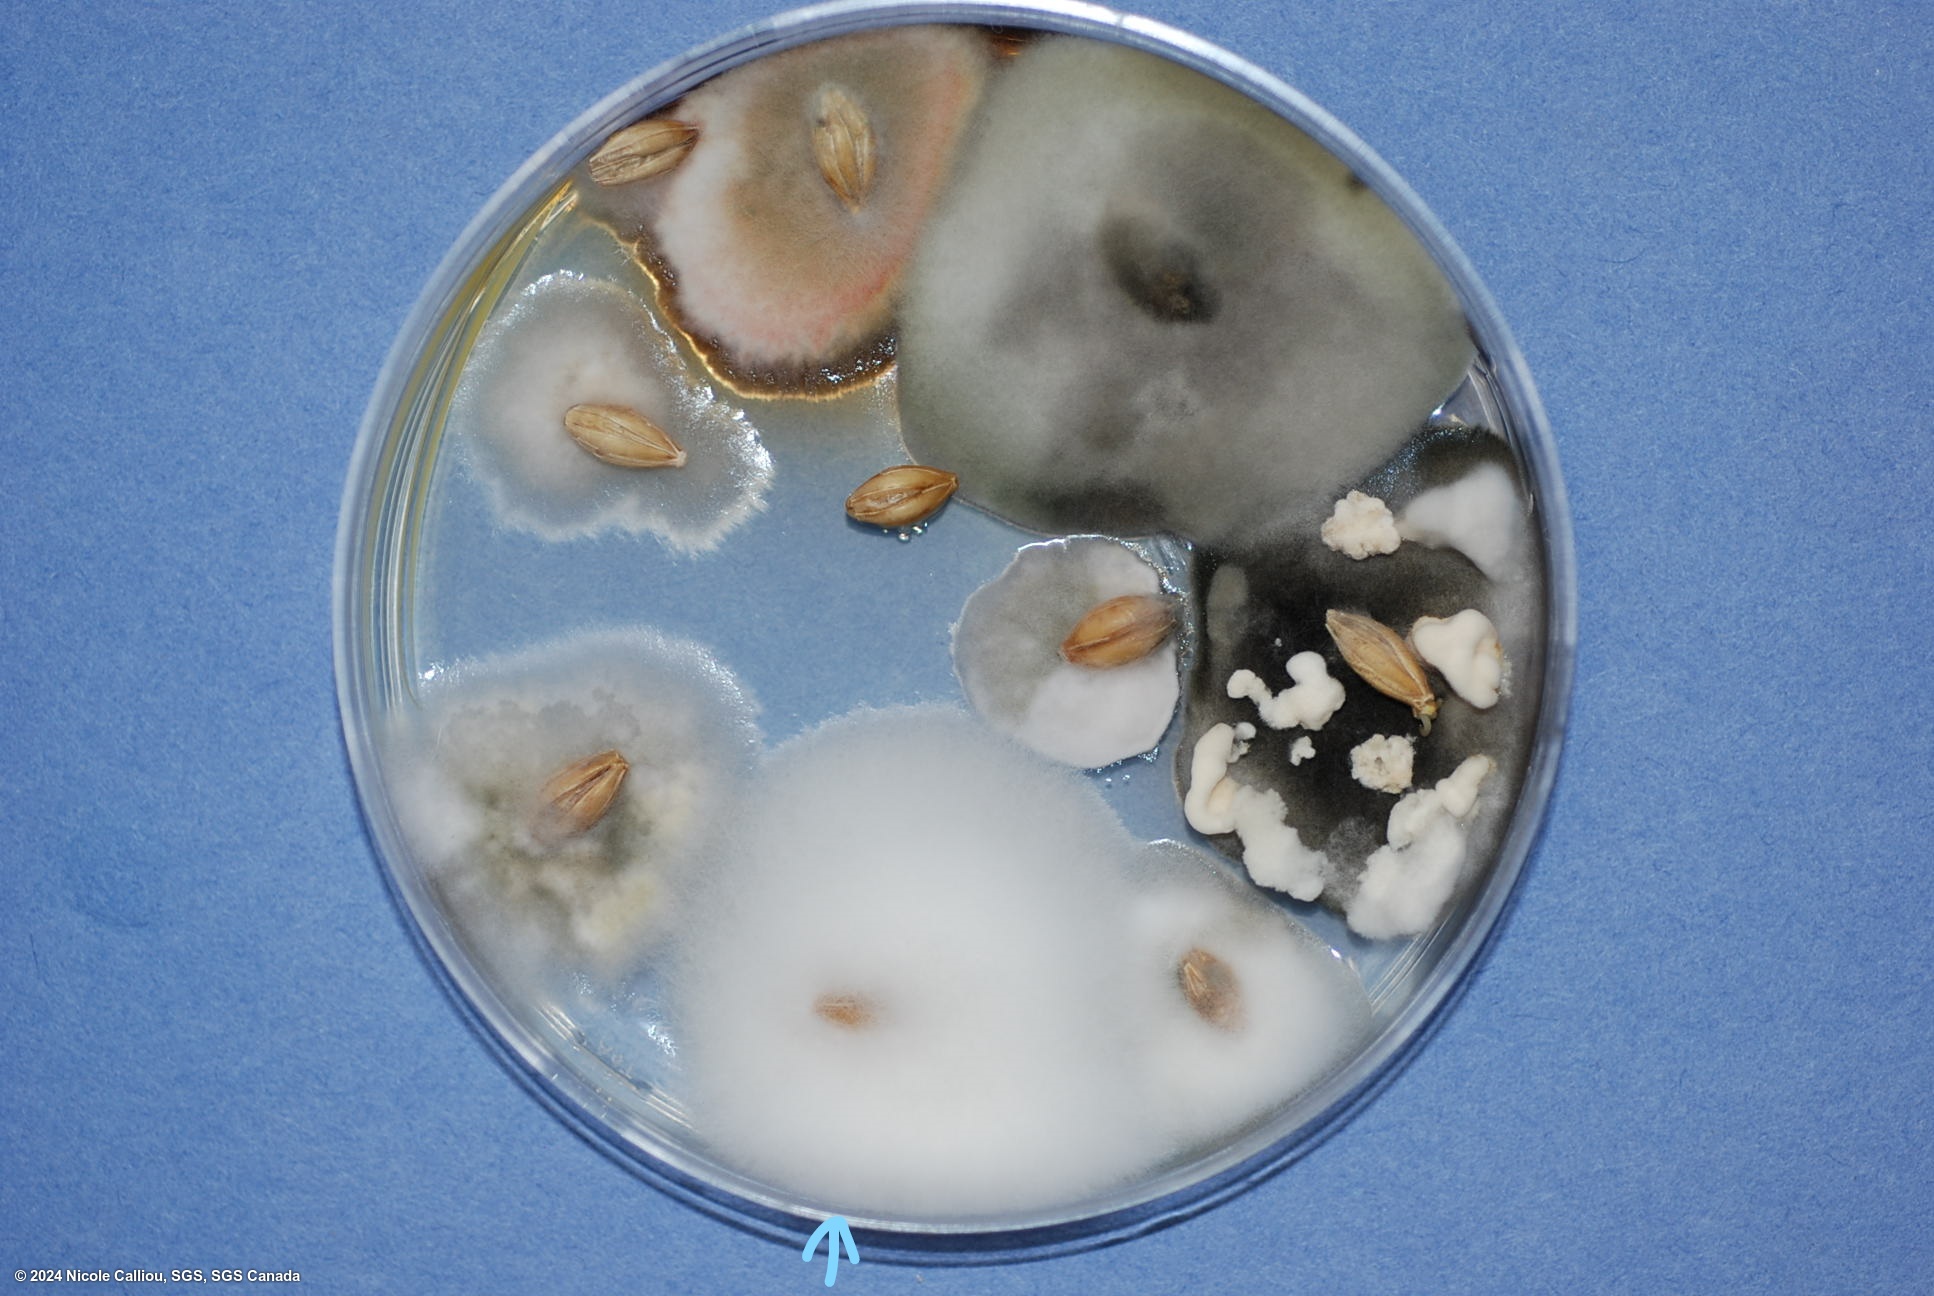
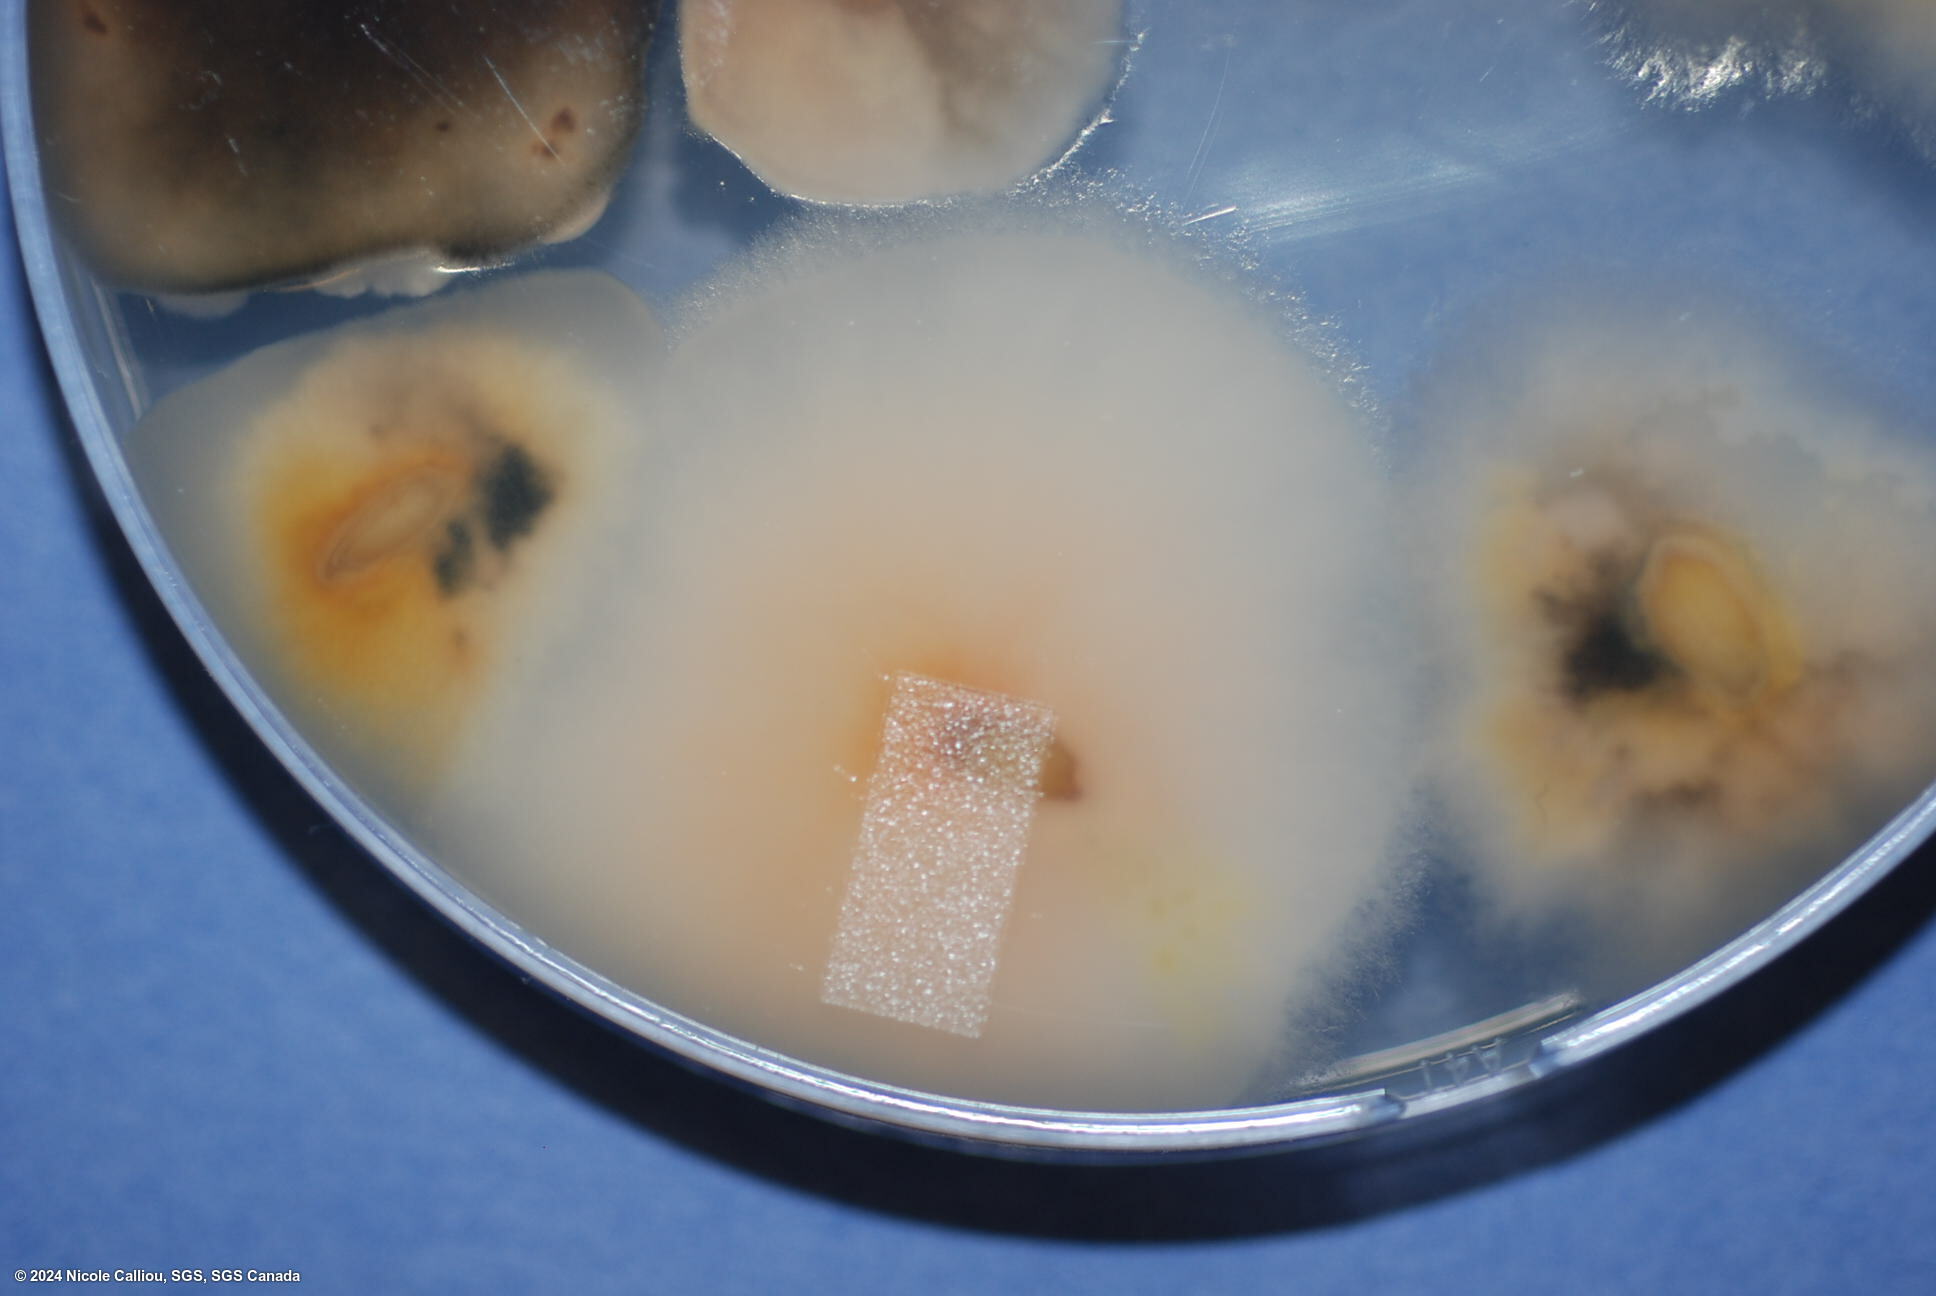

Submission
Fusarium avenaceum on Hordeum vulgare
- Credits / Owner: Nicole Calliou, SGS, SGS Canada
- Submission date: 2024-07-23 18:52:46
- Submission ID: #80
Pathogen
|
Scientific name
|
Fusarium avenaceum |
|
Genus
|
Fusarium |
|
EPPO code
|
GIBBAV |
|
Common name
|
Cereal foot rot |
|
Synonyms
|
Gibberella avenacea |
|
Crop
|
Hordeum vulgare |
Submission
Description
F. avenaceum colonies, showing the color range (from white to yellow to orange to pink) possible, with mature spores (10 days growth for spores)
| Sterilant: | 1% NaOCl |
| Sterilant time: | 4 min |
| Growth time: | 5 days |
| Lighting: | 3:1 (fluorescent:nUV), within 60cm of light. Alternating light/dark in 12 hr intervals |
| Agar: | PDA |
| Agar brand: | Neogen |
| Sample origin: | Canada |